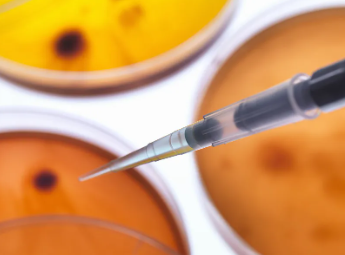
image.png

干細(xì)胞移植倉如何選擇最合適?其優(yōu)勢有哪些?
2024-10-23 09:57:34 來源: 小編 咨詢醫(yī)生
干細(xì)胞移植倉的選擇對(duì)于治療過程至關(guān)重要,本文將為您詳細(xì)解析如何挑選最合適的干細(xì)胞移植倉,并介紹其優(yōu)勢。
在選擇干細(xì)胞移植倉時(shí),以下因素至關(guān)重要:
1.技術(shù)水平
首先,要關(guān)注干細(xì)胞移植倉的技術(shù)水平。一個(gè)專業(yè)的干細(xì)胞移植倉應(yīng)具備先進(jìn)的移植技術(shù),包括干細(xì)胞的提取、分離、培養(yǎng)和移植等環(huán)節(jié)。此外,倉內(nèi)應(yīng)配備專業(yè)的技術(shù)團(tuán)隊(duì),以確保移植過程的安全和高效。
2.設(shè)施條件
設(shè)施條件是選擇干細(xì)胞移植倉的關(guān)鍵因素之一。一個(gè)理想的干細(xì)胞移植倉應(yīng)具備以下條件:
-干細(xì)胞實(shí)驗(yàn)室:具備嚴(yán)格的無菌環(huán)境,確保干細(xì)胞的質(zhì)量和活性。
-移植室:具備舒適的居住環(huán)境,為患者提供良好的恢復(fù)條件。
-醫(yī)療設(shè)備:擁有先進(jìn)的醫(yī)療設(shè)備,為患者提供全方位的醫(yī)療保障。
3.醫(yī)療團(tuán)隊(duì)
專業(yè)的醫(yī)療團(tuán)隊(duì)是干細(xì)胞移植成功的關(guān)鍵。在選擇干細(xì)胞移植倉時(shí),要關(guān)注以下方面:
-醫(yī)生資質(zhì):確保醫(yī)生具備豐富的臨床經(jīng)驗(yàn)和專業(yè)的技術(shù)水平。
-護(hù)士團(tuán)隊(duì):護(hù)士應(yīng)具備良好的護(hù)理技能和溝通能力,為患者提供優(yōu)質(zhì)的護(hù)理服務(wù)。
4.成功率和口碑
了解干細(xì)胞移植倉的成功率和患者口碑,有助于判斷其專業(yè)程度。一個(gè)優(yōu)秀的干細(xì)胞移植倉應(yīng)具備較高的成功率,同時(shí)獲得患者和家屬的好評(píng)。
以下為干細(xì)胞移植倉的優(yōu)勢:
1.治療范圍廣泛
干細(xì)胞移植技術(shù)可應(yīng)用于多種疾病的治療,如神經(jīng)系統(tǒng)疾病、心血管疾病、肝硬化、糖尿病等。此外,干細(xì)胞移植還具有抗衰老、美容、保健等功效。
2.安全性高
相較于傳統(tǒng)藥物治療,干細(xì)胞移植具有更高的安全性。移植過程中,患者無需承受手術(shù)的痛苦,且并發(fā)癥和副作用較小。
3.效果顯著
干細(xì)胞移植療法具有顯著的治療效果,許多患者在接受治療后生活質(zhì)量得到了明顯改善。
4.可持續(xù)發(fā)展
干細(xì)胞移植技術(shù)具有可持續(xù)發(fā)展的潛力,隨著科研技術(shù)的不斷進(jìn)步,未來有望應(yīng)用于更多疾病的治療。
總之,在選擇干細(xì)胞移植倉時(shí),要綜合考慮技術(shù)水平、設(shè)施條件、醫(yī)療團(tuán)隊(duì)和口碑等因素。一個(gè)專業(yè)的干細(xì)胞移植倉將為患者提供高效、安全、舒適的治療環(huán)境,助力患者重獲健康。
- 2024-10-24廣州干細(xì)胞能治冠心病嗎,干細(xì)胞移植對(duì)冠心病的好處盤點(diǎn)
- 2024-09-11干細(xì)胞再生技術(shù)哪個(gè)國家最先進(jìn),綜合排名前五名
- 2024-08-26人脂肪干細(xì)胞功效,脂肪干細(xì)胞用途和作用
- 2024-11-11打完干細(xì)胞多久有效果,其治療效果如何評(píng)估
- 2024-11-08安徽蚌埠捐贈(zèng)干細(xì)胞機(jī)構(gòu)有哪些?
- 2024-10-02嘉興人體干細(xì)胞有哪些作用,應(yīng)用前景如何
- 2024-08-06存儲(chǔ)干細(xì)胞費(fèi)用,存儲(chǔ)干細(xì)胞有什么用
- 2024-09-27貝拉醫(yī)院介紹資料
- 2024-08-16干細(xì)胞面部抗衰多少錢一次能持續(xù)多久
- 2024-09-13胚胎干細(xì)胞的研究進(jìn)展及應(yīng)用前景
- 2024-07-29干細(xì)胞去眼袋有效果嗎,干細(xì)胞去眼袋的機(jī)理是什么
- 2024-09-10怎么打干細(xì)胞效果比較好,干細(xì)胞幾種注射方法
- 2024-08-06干細(xì)胞醫(yī)療技術(shù),干細(xì)胞醫(yī)療技術(shù)發(fā)展前景
- 2024-07-18北京干細(xì)胞移植哪個(gè)醫(yī)院好,北京干細(xì)胞移植醫(yī)院排名分享
- 2024-07-18干細(xì)胞回輸治療二型糖尿病費(fèi)用多少,干細(xì)胞治療二型糖尿病的效果
- 2024-07-30干細(xì)胞捐獻(xiàn)采集過程,干細(xì)胞捐獻(xiàn)的基本條件
- 2024-07-17干細(xì)胞移植費(fèi)用大概多少錢,干細(xì)胞移植成功率介紹
- 2024-10-11干細(xì)胞技術(shù)機(jī)構(gòu)哪些知名?如何挑選權(quán)威機(jī)構(gòu)?
